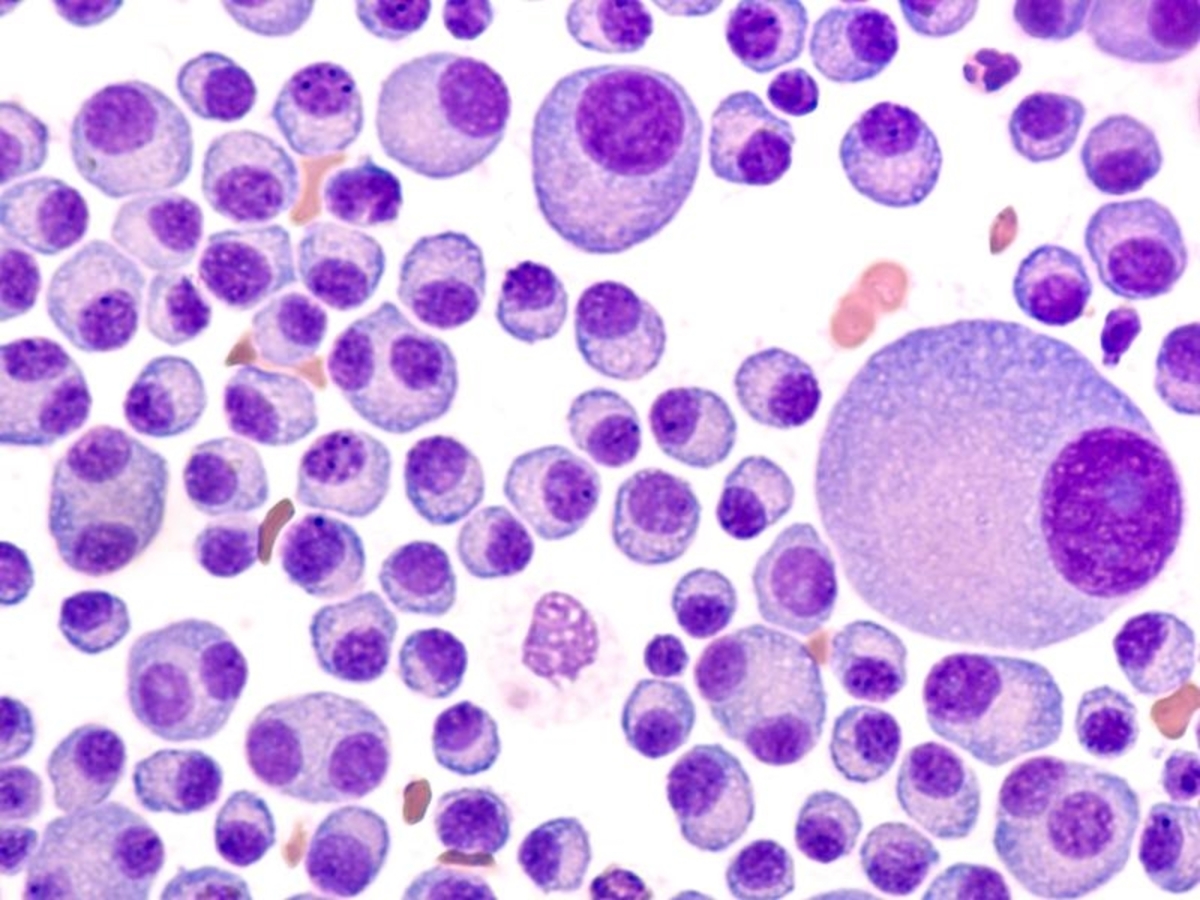

South Australian researchers are hoping to improve outcomes for patients with a common blood cancer after identifying a new protein associated with the most aggressive form of the disease.
A team from the University of South Australia and Flinders University has made the discovery in relation to multiple myeloma, with patients who have a high level of a cell adhesion protein three times as likely to die within six years.
UniSA head of vascular biology Claudine Bonder says the finding will allow multiple myeloma patients likely to have the poorest outcomes to be rapidly identified and the most potent, appropriate and available drugs to be more quickly administered.
"Newly-diagnosed patients currently undergo genetic testing to match the most significant chromosomal mutations with the most potent drugs to prevent disease progression," Professor Bonder said.
"These genetic tests can take up to two weeks which, for 20 per cent of patients with the most advanced form of multiple myeloma, significantly delays their start of treatment."
The researchers are now working on a new clinical test to quickly identify the protein and the patients who require immediate and rigorous treatment.
Multiple myeloma is a cancer that forms in white blood cells found in bone marrow.
In healthy people, plasma cells make antibodies that help the body fight diseases and infection.
Multiple myeloma occurs when the plasma cells become abnormal and overcrowd healthy blood cells in the bone marrow, causing damage to the bones, immune system and various organs.
Worldwide, about 140,000 people are diagnosed with the disease each year, including 1900 Australians.
The average life expectancy is four years.







